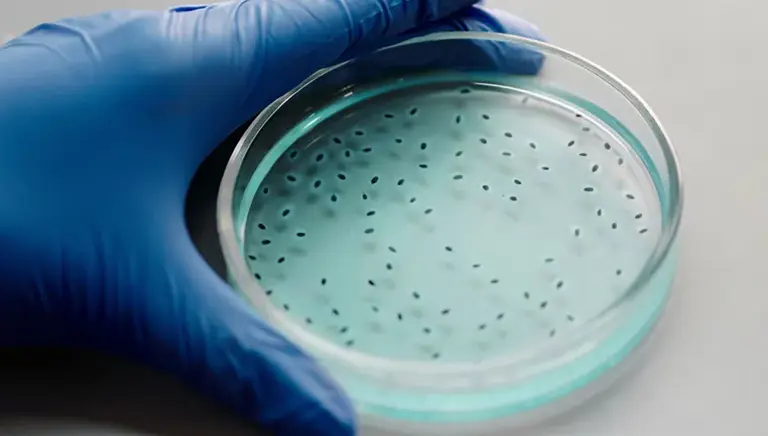

UK antibiotic subscription model key to supporting antibiotic investment
Investors need confidence and predictability if they are to invest in the fight against antibiotic resistance, finds a new report.
For the world to meet the health challenge posed by increasing antimicrobial resistance (AMR), new ways must be found to overcome the market failure that holds back the development of new antibiotics. Critical to this is greater understanding of the factors needed to persuade investors to support research and development (R&D) efforts. The latest report by the Office of Health Economics (OHE) provides valuable insights into investor views on the potential impact of a subscription model as a stimulus for the development of new antibiotics. [1]
The UK has been at the forefront of these efforts through its pioneering subscription-based funding pilot. Introduced by NHS England and NICE, the pilot sought to provide a guaranteed return on investment for two new antimicrobial treatments which have gained regulatory approval [2]. The learnings from the pilot have been adapted into a proposal for a new UK-wide scheme by NICE and NHSE.
In a new analysis, ‘Proposals for a Novel UK Antimicrobial Subscription Model: The Investor Perspective’ , the Office of Health Economics (OHE) examines the proposals from the viewpoint of international investors and considers what should be done to strengthen the pull incentives provided for investors.
OHE interviewed nine institutional financial investors, mission-led investors, and biopharmaceutical executives, and analysed the proposals for a new UK AMR subscription model to consider how such a scheme might impact global antibiotic R&D investment.
Overall, all investors agreed that the UK approach has the potential to send a hugely significant signal to other countries about the importance of pursuing similar incentives, while also showing how such initiatives can be put into action.
However, investors were clear that the UK's subscription model in isolation cannot solve the global underinvestment in new antibiotic development. A collaborative effort, involving the European Union and the United States, would be necessary to establish the minimum level of incentive to unlock investment at the scale necessary.
Investors also suggested that combining various types of incentives at a global level would be the most powerful way to boost investment, highlighting the importance of global stakeholders working together to create an environment conducive to developing new antibiotics.
While institutional investors said they would often prioritise investment decisions based on financial considerations rather than public policy implications, mission-led investors said the reimbursement incentive was key and crucial to motivating R&D investment.
Grace Hampson, OHE, Associate Director said: “The NHS England proposals represent a critical step towards creating viable markets for new antibiotics that we desperately need. In order for them to be successful, investor buy-in will be crucial.”
Paul Catchpole, ABPI Director, Value & Access Policy said: “The subscription-based approach has put the UK at the forefront of a global movement to fix the antibiotic market failure. By establishing a permanent subscription framework for antimicrobial products, the UK is setting an example for the world to follow. We must provide investors with a transparent and supportive framework if we are to combat antibiotic resistance.”
The OHE report authors propose recommendations for strengthening the UK proposals from an investor perspective to make them more predictable and deliver greater certainty. These include:
- Clarify the long-term commitment to the scheme.
- Consider a form of early advice or dialogue to enable developers (and thus investors) to understand how their product may perform against the criteria.
- Provide clarity and potentially higher flexibility in the application of eligibility criteria.
- Implement a transparent collaborative process for the review of scoring criteria and contract conditions over time.
- Share best practices and encourage the development of streamlined and harmonised subscription systems internationally.
- AMR
- Antibiotic resistance
- Anti Microbial Resistance
- Antibiotics
Last reviewed date: 02 November 2023
Next review date: 02 November 2026